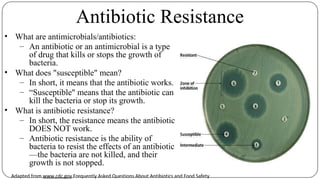
Antibiotic Resistance
• What are antimicrobials/antibiotics:
– An antibiotic or an antimicrobial is a type
of drug that kills or stops the growth of
bacteria.
• What does "susceptible" mean?
– In short, it means that the antibiotic works.
– “Susceptible" means that the antibiotic can
kill the bacteria or stop its growth.
• What is antibiotic resistance?
– In short, the resistance means the antibiotic
DOES NOT work.
– Antibiotic resistance is the ability of
bacteria to resist the effects of an antibiotic
—the bacteria are not killed, and their
growth is not stopped.
Adapted from www.cdc.gov Frequently Asked Questions About Antibiotics and Food Safety

The document discusses the historical and current use of antibiotics in livestock, highlighting their initial use for disease control and subsequent overuse, leading to antibiotic resistance in both animals and humans. It outlines economic impacts, healthcare costs due to antibiotic-resistant infections, and the need for policy regulations to curb unnecessary antibiotic use in agriculture. The document emphasizes the importance of continued research and responsible practices to preserve antibiotic effectiveness for both human and animal health.